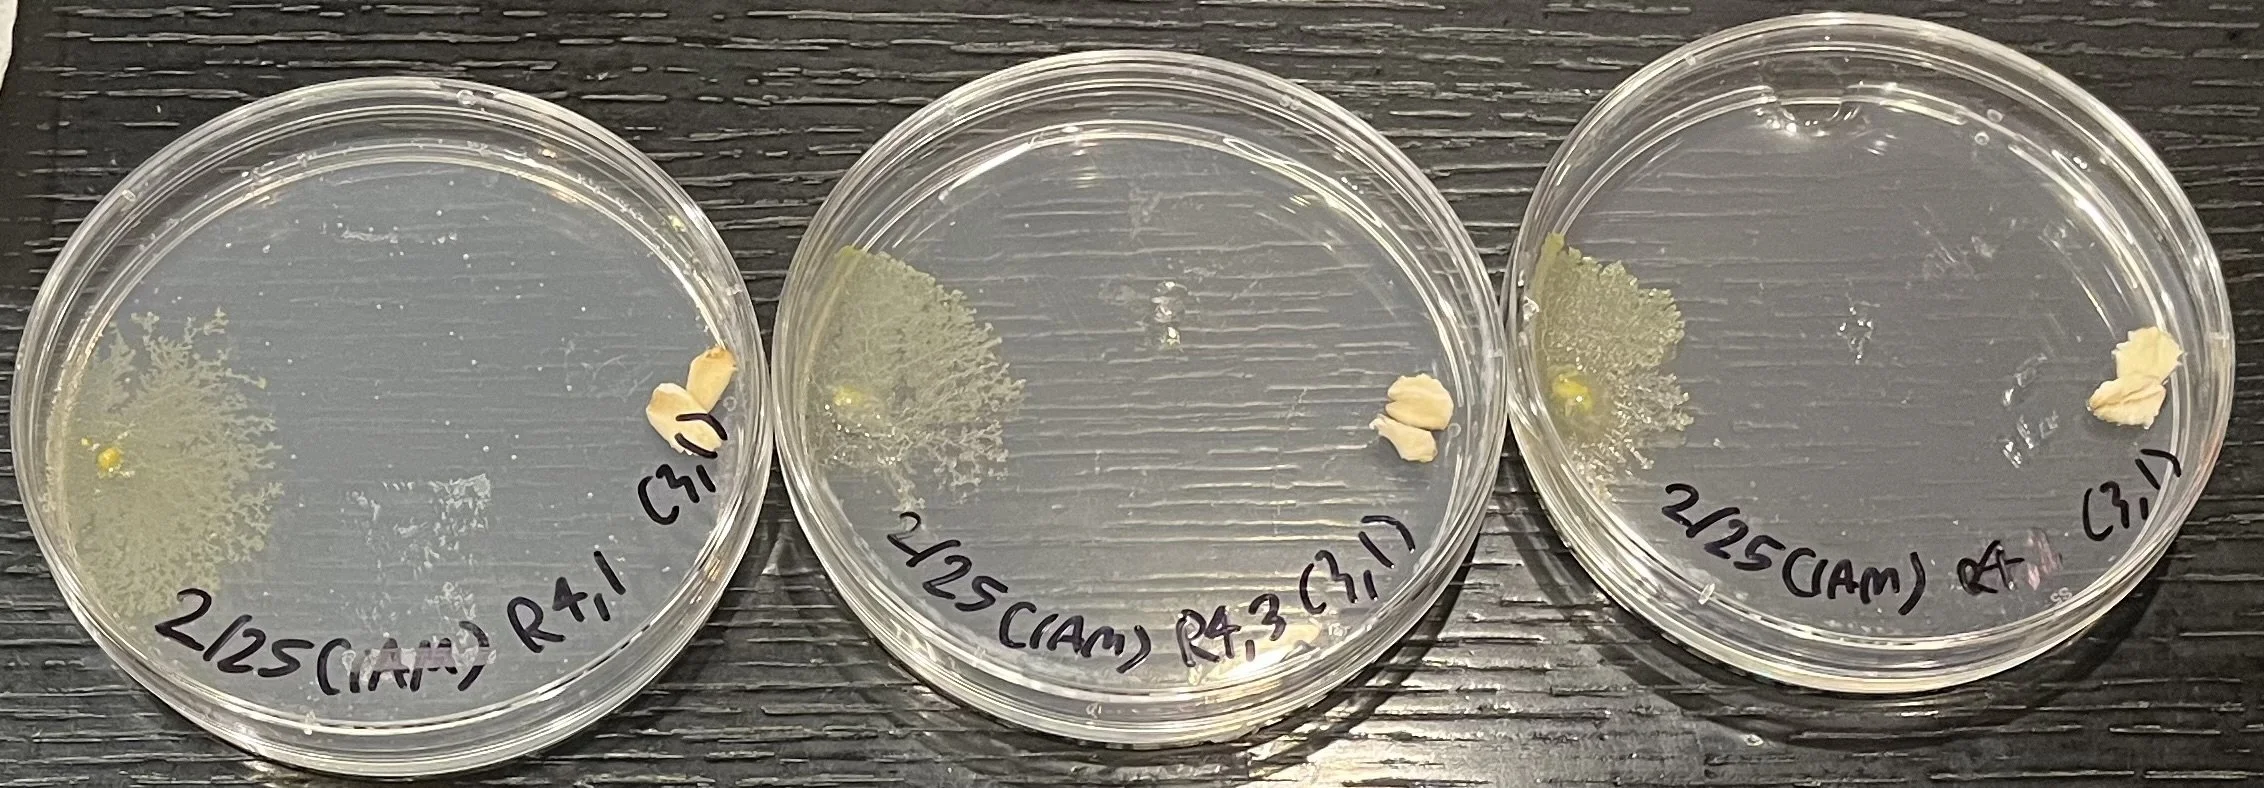
IMG_3619.jpeg
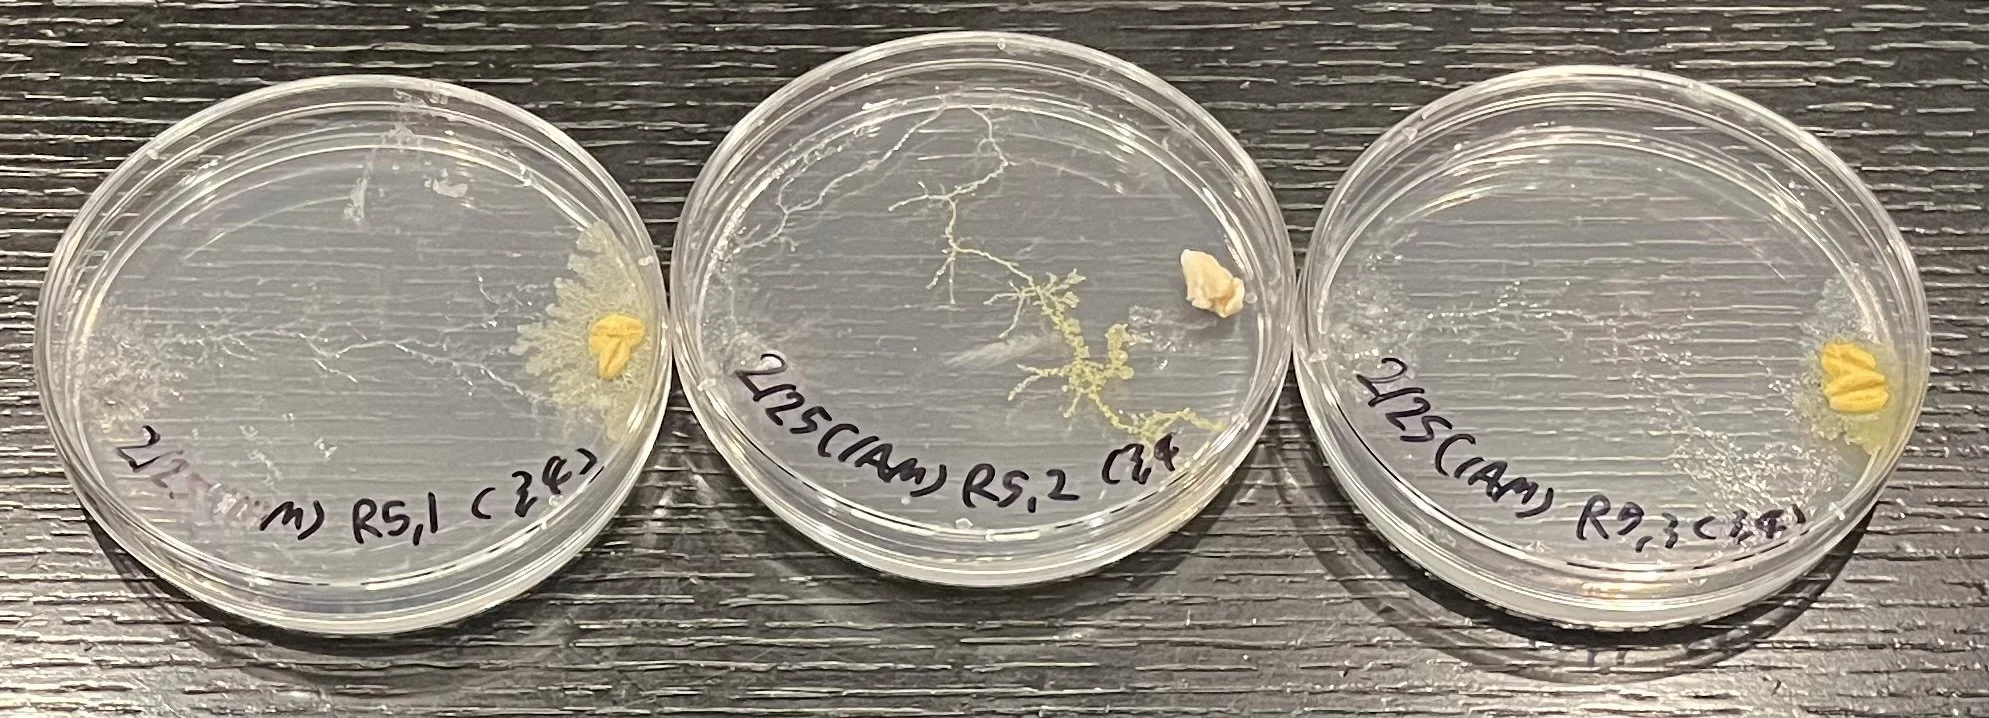
IMG_3636.jpeg

Science Fair Interviews
by Isabel Brodskiy and Benjamin Cohen
and
Noa Berson and Clover LaMorgese
The Science Academy STEM Magnet hosted their annual Science Fair on February 4th, the culmination of months of hard work. All 7th and 8th grade students participate as a requirement of their science classes, while high school students are invited to take part. The participants research a topic they're interested in, perform experiments or design and build something, and share their findings on display boards. Judges then select the winners and honorable mentions, who are awarded their prizes in an evening award ceremony. For a full list of all the winners, along with photos from the award ceremony, click here.
We interviewed several top winners to learn more about their projects.
Seventh graders Harrison Hayes Lester and Daniel Maoz earned second place for their project on how temperature affects the reproduction rates of isopods, which are small bugs similar to rolly pollies. Isopods molt every 1-2 weeks for about 5 months until they reach adulthood. Hayes and Danny tested five temperature conditions (room temperature, 75F, 80F, 85F and 90F) using groups of five male and five female isopods. These isopods were held in acrylic boxes that contained dirt, baby carrots, and isopod food, consisting of kale, broccoli and sprouts. Their hypothesis predicted that reproduction rates would increase with the temperature, but start dropping at more extreme heat. Their results supported the hypothesis. The optimal reproduction range was 75 - 80F, with 80F producing the most surviving offspring. Rates started dropping at higher temperatures, with the lowest reproduction rate being at 90F. Hayes explained the real-world importance of their project: “They are very important for cleaning up the environment” because isopods break down leaves, mold, and animal waste. Therefore, a warming climate could affect these essential links in the food web. The students chose this topic because they wanted something involving live research subjects, and with Danny’s interest in reptiles, he was familiar with isopods, so that’s what they chose. If they could redo and refine the project, they said they would include humidity testing along with heat testing, which is what they originally planned but had to abandon due to limited time.
Eight grader Stella Han earned second place for her project “Thirst Things First: How Does Hydration Affect Swim Performance?” Stella recruited 50 swimmers from her swim team. The group was about 60% female and 40% male. Participants first swam either a 50 or a 100 meter freestyle race, then drank water, rested for 10 minutes, and repeated the swims. She predicted that if swimmers drank water, then they would go faster because it would prevent fatigue and muscle cramping. Her results matched her hypothesis—they showed that hydration gave the swimmers a boost. About 90% of them improved the second time, with an average time drop of 0.5 seconds. Stella chose this topic because of her interest in swimming: “I’m very passionate about swimming and the water.” She thinks the project shows the importance of hydration for athletes. If she had to repeat the project, she would get more data from multiple locations to increase diversity in the results.
The first place winner for eighth grade was Evan Sedarat, with his advanced project about identifying the structure and function of unknown human proteins using modern bioinformatics tools, entitled “How to Use Modern Technology to Explore the Structure and Function of Unknown Human Proteins” Evan analyzed amino acid sequences from the UniProt database and used AlphaFold and SWISS-MODEL to predict 3D protein structures and functions. His project focused on three unknown human proteins. With the help of technologies such as BASIL modules, interpro databases, and blast modules, one main finding was the FCDGB protein, an IGB protein located in the cell membrane, and which his analysis showed facilitates cell membrane trafficking. Evan said he chose this topic after discovering that scientists still have about 20,500 human proteins that are not fully understood: “It made me realize how much is unknown in the world.” The project took about eight weeks, beginning in the summer of 2025. If he could redo it, Evan would use more powerful software to avoid technical slowdowns. The real-world impact of this project is significant, since understanding unknown proteins can help in advances in medicine, genetics, and disease research.
Brian Shin, a tenth grader, earned first place in the high school category with his project on the smile mold physarum polycephalum, a bright yellow organism known for its branching growth patterns, entitled “Characterizing Genes that Regulate Movement and Navigation in Myxomycete Physarum polycephalum via UV-Induced Mutagenesis.” Brian’s long-term goal is to study how genes regulate movement and navigation in the organism by using UV-induced mutations. For the school science fair, he focused on measuring the growth patterns. Using image analysis software, Brian analyzed the pixels to determine how much of the surface of the petri dishes were covered by the yellow slime mold over time. He wants to expand the project at the county level by including UV mutations and comparing different cultures. Brian originally wanted to research cancer but did not have access to a cancer lab. Instead, he chose slime mold, which is pretty similar to cancer cells in that they are both eukaryotes and in the way they propagate. With guidance from a biologist mentor, he began planning the project in October.
Noa Berson and Clover LaMorgese interviewed 7th grader Norah Goodman, who won first place in her division with a project entitled “Building a Cooler City - One Roof at a Time.” She explained that the goal of her project was “to find out which roofing material would be best for the environment and overall temperature”. Different types of roofing material are important for their impacts to the environment because roof types that keep houses cooler use less air conditioning, and since air conditioning emits CO2, material that helps keep houses cooler creates less air pollution.
The project used a wooden base for the houses, which were approximately 8cm x 6cm x 12cm, and six different roofing materials. The roof types were black metal tiles, white metal tiles, red terracotta, moss, white terracotta, and asphalt shingles. To do the experiment, she assembled the wooden houses, attached the roofs, and put small thermometers inside them. She also put a lightbulb over them to simulate sunlight. She recorded the temperatures every 5 minutes in several different scenarios, such as moving the houses inside and outside, and making the light less strong. The coolest temperature overall was the green moss, at a cool 63.3 degrees Fahrenheit. And the highest temperature was the asphalt shingles, at a sweltering 148.6 degrees Fahrenheit. All of these results and more can be found on the chart below, which compiles the most important data points.
Norah stated that the biggest struggle of doing the experiment was “making sure that my data was consistent, and finding the best way to represent my houses, but once I got there, it was simpler." She said that if she could do it again, she would “use different things [roof materials], and also instead of using possibly slightly different models, and I would use magnet roofs” However, she was pretty pleased with how her project turned out: “My hypothesis was supported because I thought thought the darker colors would do less well; however, I thought that the white metal would perform better.” Norah said that she would love to build on this project in the future, because “testing different bases and seeing if that affected [the overall temperature] would be interesting. Also the angle of the house, as well as other roof materials." When asked if there was anything she thought people should know about her project, she replied, “I think people should care because global warming is increasing and if everyone did their part, it would help the environment a lot.”
This year’s Science Fair showed how creative and capable students at our school can be. From studying helpful bugs to analyzing human proteins, these students were able to showcase their knowledge and passion for science. All of their projects are connected to real-world problems, and many students are already thinking about how to improve their research and expand even more.